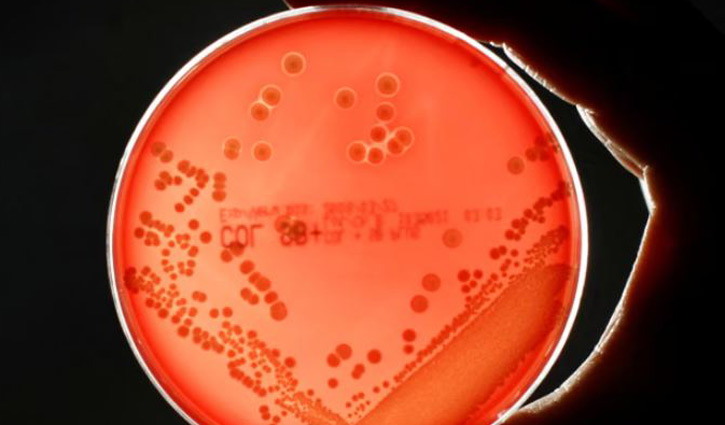
সুপারবাগের কারণে বিশ্বব্যাপী মারা যাবে লাখ লাখ মানুষ

সুপারবাগের কারণে বিশ্বব্যাপী মারা যাবে লাখ লাখ মানুষ
সুপারবাগের কারণে বিশ্বব্যাপী আরো লাখ লাখ মানুষ মারা যেতে পারে। এর ফলে ২০৫০ সালের মধ্যে বিশ্ব অর্থনীতিতে বছরে ২ ট্রিলিয়ন ডলারের ক্ষতি হতে পারে।
যুক্তরাজ্য সরকারের অর্থায়নে পরিচালিত একটি গবেষণায় দেখা গেছে যে, সমন্বিত পদক্ষেপ না নিলে অ্যান্টিমাইক্রোবিয়াল রেজিস্ট্যান্স (এএমআর) বা অ্যান্টিবায়োটিক প্রতিরোধী ভাইরাসের এর বর্ধিত হার পরবর্তী ২৫ বছরে বিশ্বব্যাপী বার্ষিক জিডিপিতে ১ দশমিক ৭ ট্রিলিয়ন ডলারের ক্ষতির কারণ হতে পারে।
সেন্টার ফর গ্লোবাল ডেভেলপমেন্ট নামের একটি গবেষণা প্রতিষ্ঠানের গবেষণায় দেখা গেছে, মার্কিন যুক্তরাষ্ট্র, যুক্তরাজ্য এবং ইইউ অর্থনীতি সবচেয়ে বেশি ক্ষতিগ্রস্ত হবে। এর ফলে বিশ্বব্যাপী সহায়তা প্রকল্পগুলো বন্ধ করে দিতে পারে এই দেশগুলো।
বৃহস্পতিবার যুক্তরাজ্য সরকার ঘোষণা করেছে যে তারা বৃহত্তর সাহায্য হ্রাসের অংশ হিসেবে নিম্ন ও মধ্যম আয়ের দেশগুলোতে এএমআর মোকাবেলায় ব্যবহৃত ফ্লেমিং তহবিলে সহায়তা বাতিল করছে। ট্রাম্প প্রশাসন তাদের বৈদেশিক সাহায্য বাজেটে ৯ বিলিয়ন ডলারের কাটছাঁট নিশ্চিত করেছে। অন্যদিকে বেশ কয়েকটি ইউরোপীয় দেশও বৈদেশিক সাহায্যের উপর ব্যয় কমিয়েছে।
গবেষণার প্রধান লেখক এবং সেন্টার ফর গ্লোবাল ডেভেলপমেন্টের পলিসি ফেলো অ্যান্থনি ম্যাকডোনেল বলেন, “যখন আমরা অ্যান্টিমাইক্রোবিয়াল রেজিস্ট্যান্সের অর্থনৈতিক প্রভাব নিয়ে আমাদের গবেষণা পরিচালনা করি, তখন ধারণা করা হয়েছিল যে প্রতিরোধের হার ঐতিহাসিক প্রবণতা অনুসরণ করেই চলবে। তবে, মার্কিন যুক্তরাষ্ট্র অফিসিয়াল ডেভেলপমেন্ট অ্যাসিস্ট্যান্সে হঠাৎ করে কাটছাঁটের মাধ্যমে তাদের সাহায্য ব্যয় প্রায় ৮০ শতাংশ কমিয়েছে; যুক্তরাজ্য মোট জাতীয় আয়ের শূন্য দশমিক ৫ থেকে শূন্য দশমিক ৩ শতাংশ সাহায্য কমানোর ঘোষণা করেছে এবং ফ্রান্স, জার্মানি ও অন্যান্যদের উল্লেখযোগ্য হ্রাস, আমাদের গবেষণার সবচেয়ে হতাশাজনক পরিস্থিতির সাথে সামঞ্জস্য রেখে প্রতিরোধের হার বাড়িয়ে তুলতে পারে।”
ইনস্টিটিউট ফর হেলথ মেট্রিক্স অ্যান্ড ইভালুয়েশন এর তথ্য অনুসারে, ২০৫০ সালের মধ্যে এএমআর-এর কারণে মৃত্যু ৬০ শতাংশ বৃদ্ধি পাবে বলে আশঙ্কা করা হচ্ছে। মার্কিন যুক্তরাষ্ট্রে ১৩ লাখ ৪০ হাজার এবং যুক্তরাজ্যে ১ লাখ ৮৪ হাজার মানুষ প্রতি বছর অ্যান্টিবায়োটিক প্রতিরোধী ব্যাকটেরিয়া থেকে মারা যাবে বলে পূর্বাভাস দেওয়া হয়েছে। অন্যদিকে ওষুধ-প্রতিরোধী ব্যাকটেরিয়া থেকে গুরুতর অসুস্থ হওয়ার সংখ্যাও বৃদ্ধি পাবে বলে আশঙ্কা করা হচ্ছে।
সুপারবাগ হাসপাতালে ভর্তি হওয়া মানুষের সংখ্যা বৃদ্ধি করে এবং দীর্ঘ ও আরো নিবিড় হাসপাতালে থাকার ব্যবস্থা করে, দ্বিতীয় সারির চিকিৎসা ব্যয়বহুল এবং আরও জটিল যত্ন, যার অর্থ প্রতিরোধী সংক্রমণের চিকিৎসা করা অ্যান্টিবায়োটিক কার্যকরী সংক্রমণের তুলনায় প্রায় দ্বিগুণ ব্যয়বহুল।
ঢাকা/শাহেদ



































